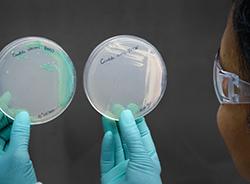
Air Technology Consultants

PuriFi Labs
8901 E Pima Center Pkwy Ste 250
Scottsdale, AZ 85258
PuriFi Labs, located in Scottsdale, AZ, specializes in innovative air quality solutions, offering a range of products designed for both residential and commercial applications. The company is dedicated to improving environmental health through advanced testing, reporting, and certification processes.
With a commitment to transparency, PuriFi Labs provides users with clear insights into their privacy practices and the types of information collected through its app and websites. Their focus on user privacy and data protection reflects a modern approach to customer service and interaction.
Generated from the website
Also at this address
See a problem?
You might also like
Partial Data by Infogroup (c) 2024. All rights reserved.